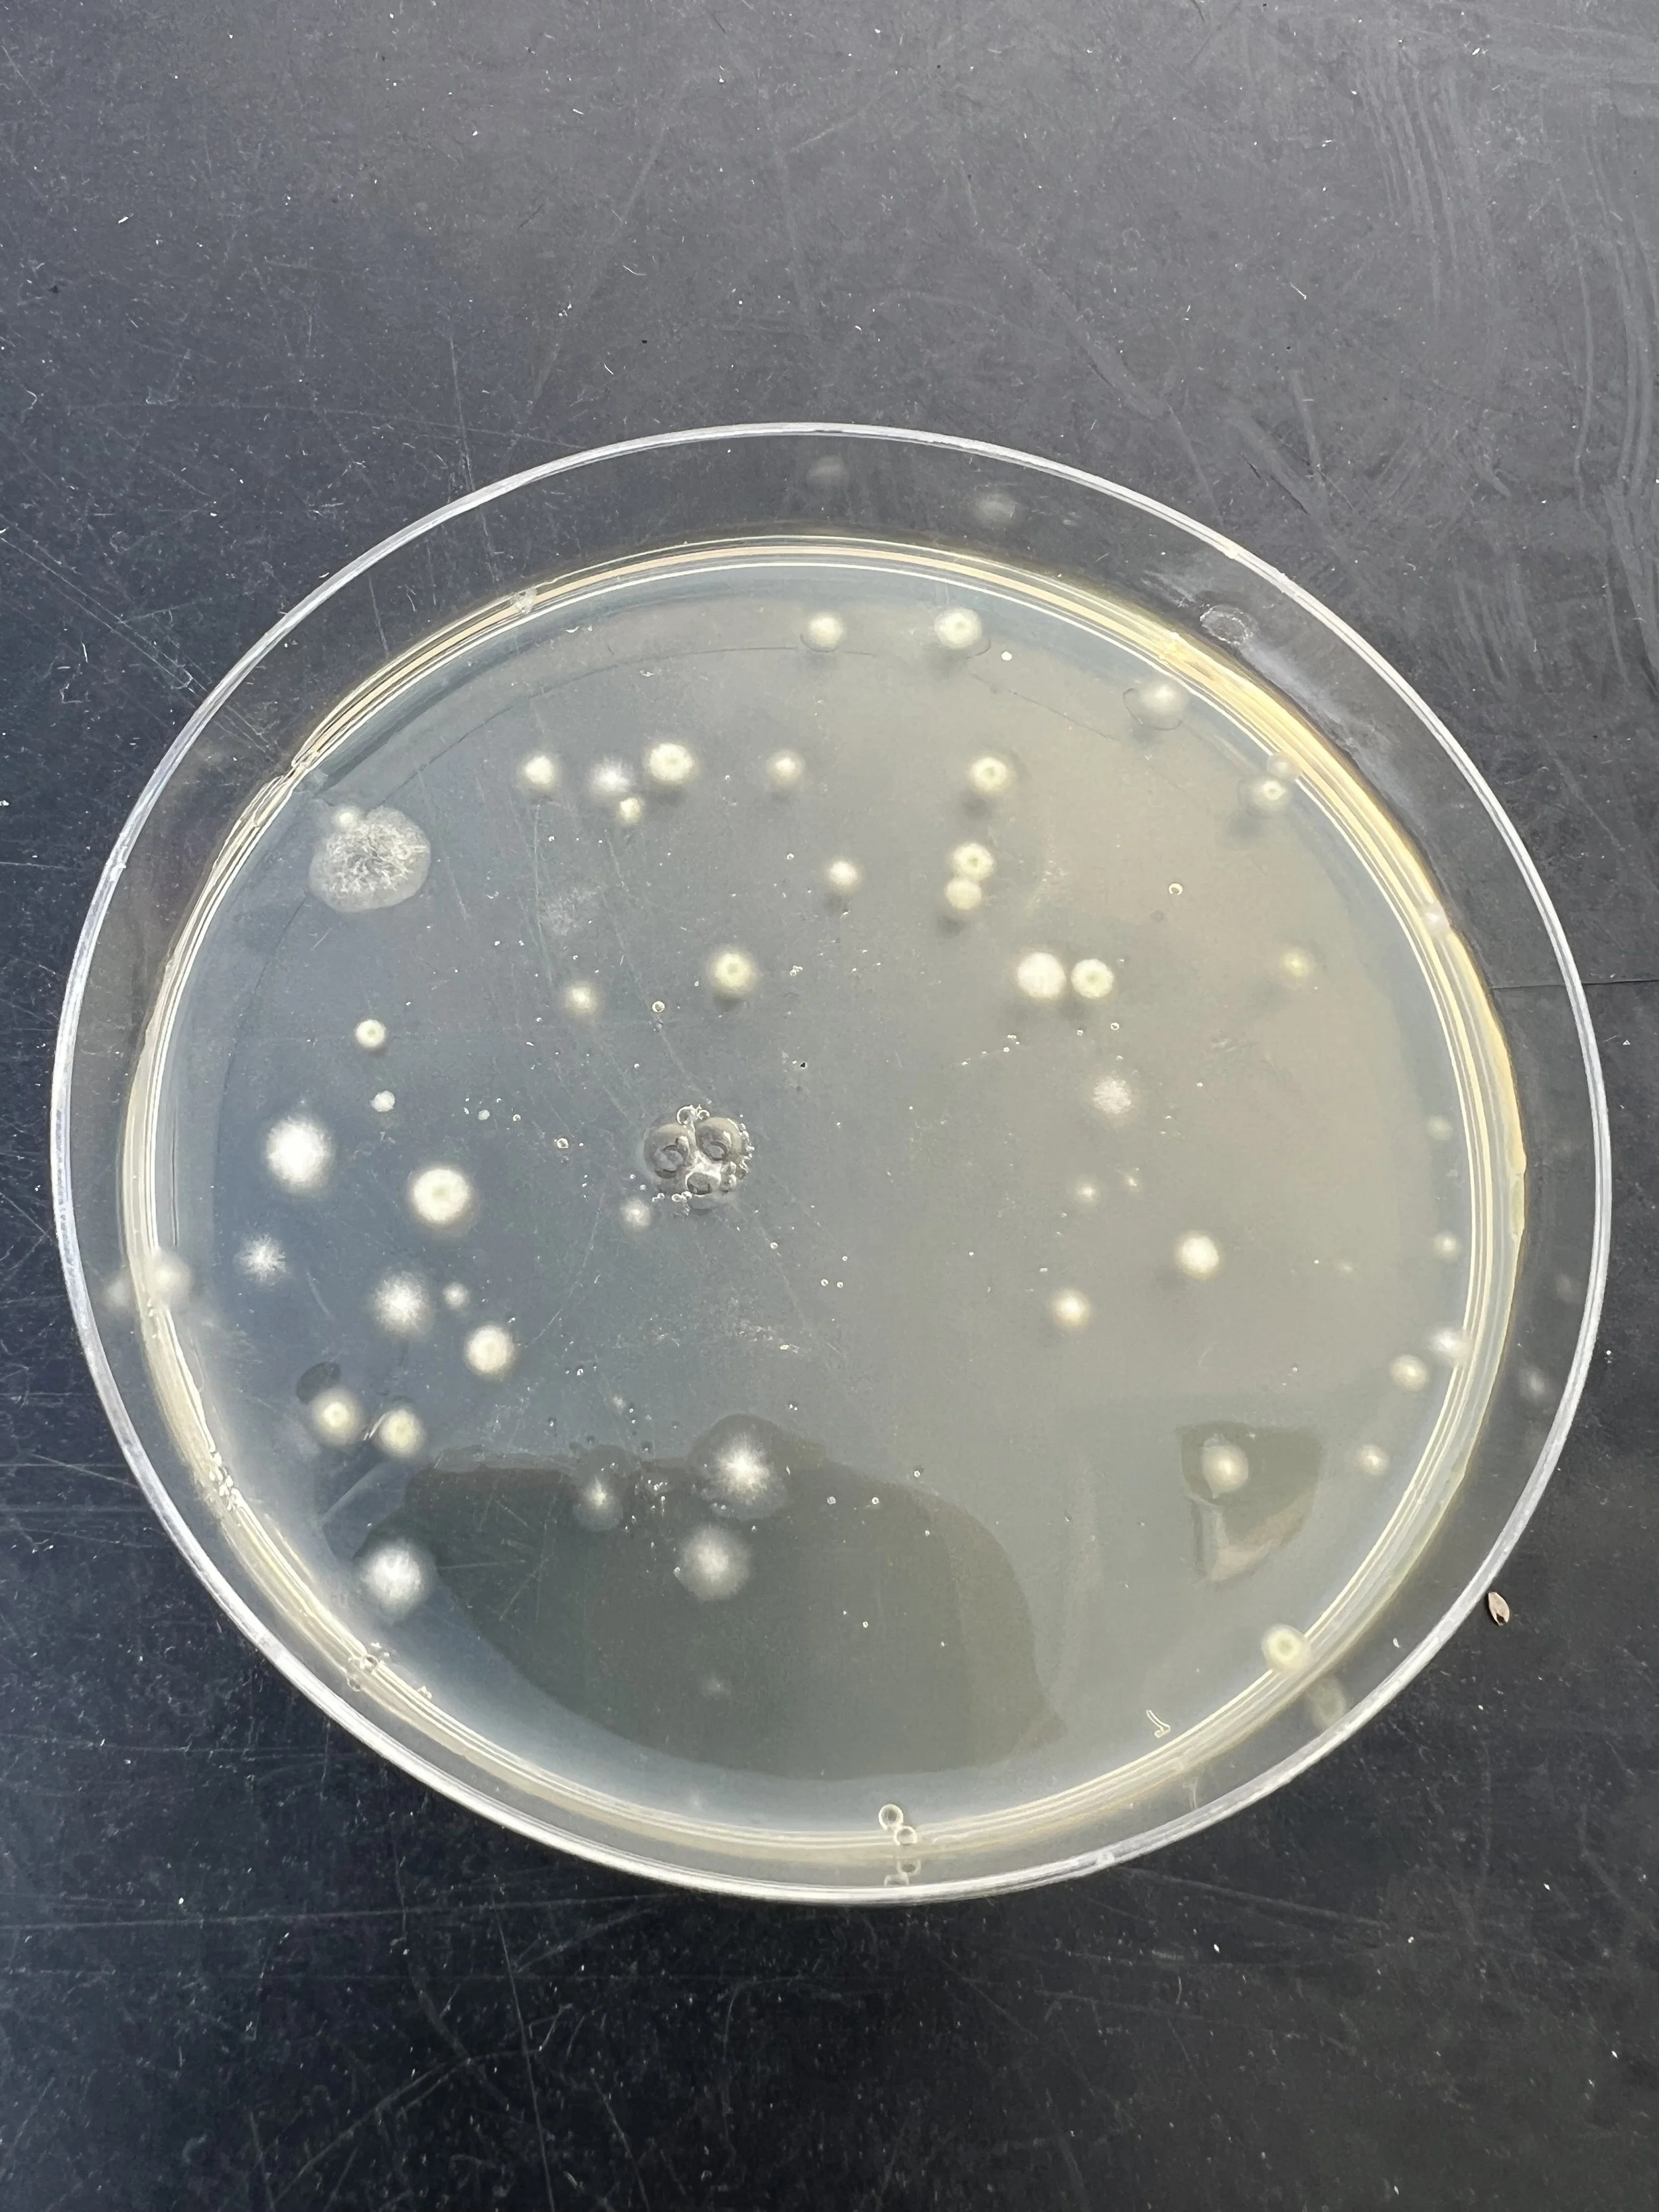

Our Services
Window Cleaning
Our professional window cleaning service ensures that every pane is crystal clear, allowing natural light to illuminate your space. We meticulously clean both interior and exterior windows, removing dirt, grime, and streaks for a spotless finish. Whether it’s a residential property or a commercial building, we use the latest tools and techniques to reach even the most challenging areas, ensuring your windows are not only clean but also contribute to a bright, inviting environment. Trust Wrighteous Cleaning Service to deliver a gleaming view, every time."
Pressure Washing
"Revitalize your property's exterior with our expert pressure washing services. At Wrighteous Cleaning Service, we use high-powered, eco-friendly pressure washing techniques to remove dirt, mold, mildew, and stains from a variety of surfaces, including driveways, sidewalks, decks, patios, and building exteriors. Our team carefully adjusts the pressure to match the surface type, ensuring a thorough clean without causing damage. Whether you need to freshen up your home’s exterior or maintain a pristine commercial space, our pressure washing service will leave your property looking like new."
New addition Services we are offering
Your Partner in Excellence for a Clean, Healthy, and Organized Space
We are excited to announce the expansion of our services to better meet your needs! Wrighteous Cleaning Service now offers the following additional services:
1. Painting Services
• Transform your home or business with professional interior and exterior painting.
• High-quality materials and a flawless finish to bring new life to your space.
2. Mold Testing and Removal
• Ensure your home or workplace is safe and healthy.
• Expert mold inspection, testing, and removal to protect you and your loved ones.
3. Moving Services
• Simplify your next move with our reliable and efficient team.
• Packing, transportation, and unpacking tailored to your needs.
At Wrighteous Cleaning Service, we are committed to delivering excellence, efficiency, and care in every task we undertake. Whether you need a fresh coat of paint, mold remediation, or help relocating, we’ve got you covered!
Contact us today for a free consultation or quote.
Car Detailing
Car Detailing Services
Experience a meticulous clean and rejuvenation for your vehicle with our comprehensive car detailing services at Wrighteous Cleaning Services. Whether you're preparing your car for sale, enhancing its appearance, or simply treating it to a thorough clean, our expert team is dedicated to delivering exceptional results that restore your car’s beauty and protect its value.
Our Car Detailing Process Includes:
Exterior Wash: We start with a thorough exterior wash using high-quality, pH-balanced car shampoos to remove dirt, grime, and contaminants. Our process includes hand washing and rinsing to ensure every surface is clean without causing scratches.
Clay Bar Treatment: To remove embedded contaminants and smooth the surface, we apply a clay bar treatment. This step helps to restore the paint’s smoothness and prepares it for polishing.
Polishing: We use advanced polishing techniques to remove minor scratches, swirl marks, and oxidation. This step enhances the paint’s clarity and shine, giving your car a polished, like-new appearance.
Waxing: To protect the paint and provide a glossy finish, we apply a premium wax. This layer shields the paint from environmental elements and keeps it looking brilliant.
Interior Cleaning: Inside the vehicle, we meticulously clean all surfaces, including vacuuming carpets and upholstery, dusting and wiping down dashboard and console areas, and cleaning windows and mirrors. We also use specialized products to treat leather, fabric, or vinyl surfaces, ensuring a deep clean and fresh scent.
Engine Bay Cleaning: We offer a detailed engine bay cleaning service to remove dirt, grease, and grime. This not only improves the engine's appearance but can also help with maintenance and diagnostics.
Final Touches: We complete the detailing process with final touches, such as tire dressing, trim conditioning, and any additional services requested. Our goal is to ensure every detail of your car is attended to and that you are completely satisfied with the results.
Why Choose Us?
Experienced Detailers: Our team is skilled in all aspects of car detailing, using the latest techniques and equipment to deliver superior results.
Quality Products: We use high-quality, safe products that protect and enhance your vehicle’s appearance, ensuring long-lasting results.
Attention to Detail: We take pride in our meticulous approach, ensuring every aspect of your vehicle receives the care and attention it deserves.
Treat your car to the ultimate clean and shine with Wrighteous Cleaning Services. Contact us today to schedule your car detailing appointment and enjoy a vehicle that looks and feels like new!